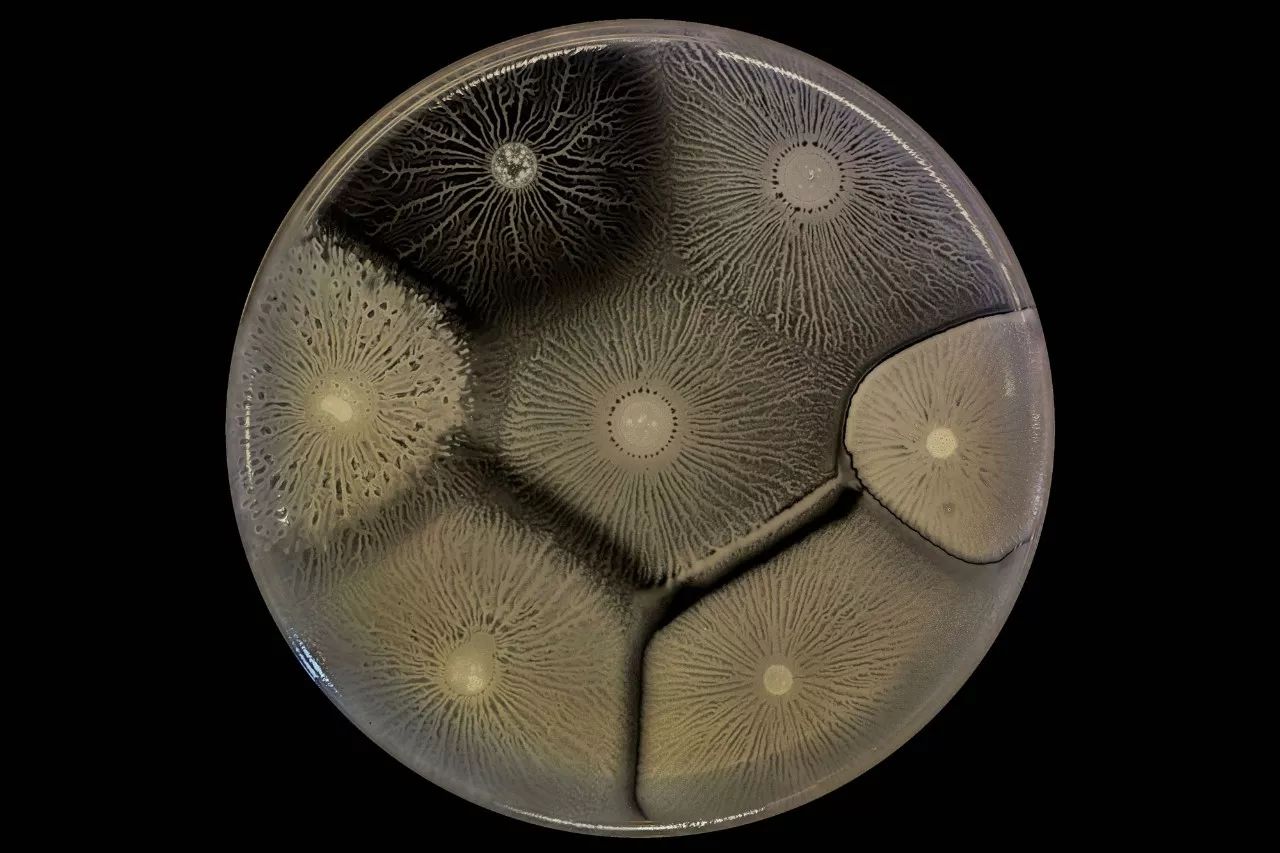

不要小看单细胞的细菌,它们可能真的拥有“智慧”
多头绒泡菌(Physarum polycephalum)形成一个细胞质管状网络,遍布了整个平面
撰文 John Rennie
图片 Lucy Reading-Ikkanda
翻译 何伟雄
审校 魏潇
我们通常并不会将智力与微生物联系在一起。因为人们没有理由认为细菌,黏菌和类似的单细胞生命形式具有真正的智力所必须的意识,知性或其他能力。然而当这些细胞大量地聚集在一起时,它们解决问题和操控周边环境的惊人才能便开始显现。
这些行为可能通过几十亿年的进化而被编码到这些微生物的遗传密码中,从某种意义上来讲,细胞,与通过编程从而可以用复杂方式应对环境的机器人,也并没有太大区别。如果我们可以谈论机器人的人工智能,那么我们也不该低估微生物所具有的智慧。
在显微镜下,细胞的集体智慧所驱使的令人难以置信的运动显示出了惊人的美丽。自 1983 年以来,哈佛大学医学院微生物学和免疫生物学教授,微生物科学计划联合主任罗伯托•考尔特(Roberto Kolter)建立了一个研究这些现象的实验室。最近,他们研发了一种技术,能够可视化这些进程。在九月出版的摄影集《生活在视线边缘:微生物世界的摄影探索》(哈佛大学出版社)(Edge of Sight: A Photographic Exploration of the Microbial World (Harvard University Press))中,考尔特和他的合著者,实验室的研究员和成像专家斯科特•奇米列斯基(Scott Chimileski)为我们提供了科学和艺术两个角度,来欣赏这些美丽的微生物,并且带领读者窥见真正存在于我们脚下的细胞世界的奇观。
延伸、再延伸
黏菌中的多头绒泡菌(Physarum polycephalum)很多时候并不具有微生物的特征:在其生命周期中的活动、变形阶段,它会渗透到森林地上的落叶腐物中,像一滩巨大的网状黄色凝胶。尽管它很巨大,多头绒泡菌依然是一个单细胞生物,它拥有成千上万的细胞核,漂浮在连续的细胞质中。在这种形态下。多头绒泡菌是一个十分高效的猎手。当细胞膜上的传感器检测到优质的营养源时,蛋白质构成的收缩网络(与人类肌肉中发现的蛋白质存在密切联系)开始向该方向泵送细胞质流,促使菌体向其所需的方向延伸。
高倍率下的多头绒泡菌通过巨大的单一细胞猛烈地泵送细胞质流
这种细胞质的流动可以让粘菌向营养物质方向前进,并有可能铺满平面。
但是,多头绒泡菌不仅仅是条件反射性地向食物延伸。当它向一个方向延伸时,细胞内传输的信号能够阻止它沿着错误的路线做无用功地推动。此外,多头绒泡菌已经发展出一种可以探测地形的系统,并记住不要去哪里:当它们移动时,它们会留下一个半透明的化学痕迹,告诉它们哪些区域不值得再去探索。
当绒泡菌探索一个地区并发现该区域缺乏营养物质后,它留下一个化学痕迹作为一种外部记忆,告诉粘菌不要再去那里。
当我们通过显微镜,观察悬浮在载玻片液体中的细菌时,简单来说它们看上去像是一群简单独立的细胞。然而事实是,在野外,大多数细菌是高度群居的。一些细菌个体会独自在环境中游动,但是大多数细菌喜欢生活在地表上的被称为生物膜(biofilm)的紧凑型群落中(那些单独的个体往往是生物膜的分支,试图扩张到新的地方)。
在绿浓杆菌生物膜的高倍放大扫描电子显微照片中,单个杆状细菌通过称为纤毛的毛状结构相互连接。芽孢杆菌属细菌分泌细胞外基质,包裹细胞并帮助它们形成更结构化的群落。
生物膜不仅仅是微生物的密集堆积。从绿脓杆菌(Pseudomonas aeruginosa)的图像中可以看出,它们还具有细致的内外功能结构,为细胞的集体命运负责。生物膜被刚果红染料(Congo red dye)染色,与细胞分泌的作为菌落支架的细胞外基质蛋白结合。生物膜布满深深褶皱的表面使细菌吸收氧气的区域最大化; 也可能有助于它们汲取营养,有效地排出废物。
当生物膜扩大时,它发展出更复杂的内部结构。大量不同位置的细菌也可能发挥更多的特异化功能。
在生物膜内,细菌会分工去将维持菌落的生存,并分化为具有不同功能的“角色”。 例如,在常见的土壤细菌——枯草芽孢杆菌(Bacillus subtilis)的生物膜中,一些细胞分泌细胞外基质并固着在原位,另一些细胞则保持能动性; 生物膜边缘的细胞可能会分裂生长,而另一些细胞则释放孢子,帮助群落在艰苦的生存条件下生存下去,并占据新的地方。
这种枯草芽孢杆菌生物膜的褶皱结构有助于确保其中的所有细菌的氧气供给(左)。 生物膜的三维数字扫描模型有助于说明细菌群落如何改变其结构(右)。
有人可能会问,为什么自然选择会倾向于细胞间的这种集体行为,而不是更为猖獗的个人主义。部分答案可能是进化理论家所说的包容适应性:就生物膜内的细菌而言,个体的牺牲,能被每个细胞的数百万“亲属”的增加的适应性所抵消。但也可能是生物膜内的每一个角色都有其进化优势:边缘的细胞最容易受到伤害,必须大力繁殖才能扩大生物膜,但也能获得最多的营养和氧气。内部的细胞依赖于其他细菌的提供重要给养,但它们可能会生存更长的时间。
菌群的移动
生物膜并不总是生长在固体上。下图这些枯草芽孢杆菌正在形成一个菌醭——在水和空气的交界面的一种浮动生物膜。参与菌醭形成的遗传途径基本上与生长在岩石上的途径相同,它们可以根据需要、通过改变细胞外基质中蛋白质的精确混合配比来适应不同栖息地的环境。
细菌也可以在非固体表面生长,这种枯草芽孢杆菌培养物通过在烧杯中的气 - 液界面上形成菌醭
扩张式的生长并不是微生物群落移动的唯一途径。下图中枯草芽孢杆菌正在进行一种叫做树枝状群游(dendritic swarming)的行为,在这种行为中,细胞群迅速向外分枝扩展,可以有效地铺满一个平面。当生物膜检测到自身处于营养富足的环境中时,会进行群游:群游有助于生物膜在任何处于竞争关系的群落到达之前,充分利用这个宝贵的区域。
生物膜中的细胞至少要发生两个重要分化才能使得群游成为可能。首先,膜外围的能动细胞会长出额外的鞭毛,使他们能够更有力地游动。其次,一些边缘细胞也会开始分泌表面活性剂,这种光滑的物质可以使能动细胞在光滑平面上更快速地滑动。
当生物膜在扁平的培养皿中生长时,群游的生物膜的树状结构整齐分明:它们彼此延伸并卷曲在一起,但是它们不会交叉。这似乎部分是由于表面活性剂堆积在生物膜的枝干周围作为屏障。同样,在实验室中,一些细菌更倾向于在阶梯状的结构中群游。这种群游模式的选择对自然界中细菌的影响仍然是一个谜。
这些细菌进行了树状群游的行为,使得微生物群落迅速扩展到理想的资源丰富的环境中
在下面的延时摄影中展示了蕈状芽胞杆菌(Bacillus mycoides)在实验室条件下生长出的生物膜的另一种行为——螺旋迁移。这些细菌细胞按照顺时针或逆时针卷曲的方式生长成长链或长丝。根据奇米列斯基的说法,这种螺旋运动的具体优点仍在研究之中,但它们一定是很重要的,因为芽孢杆菌很擅长接管可利用的环境。他解释说:“蕈状芽胞杆菌是土壤中最容易培养的细菌之一。当科学家们从土壤中分离出微生物并在琼脂培养皿上生长时,特别是在室温下,“蕈状芽胞杆菌通常会布满整个培养皿并压倒所有其他微生物。出于这个原因,对于许多微生物学家来说,这是一种“令人讨厌的物种”。
螺旋迁移是土壤细菌蕈状芽胞杆菌所青睐的行为。这些细胞的群落通过形成细长的丝状体扩张,进行细丝顺时针或逆时针盘绕。生长方向是菌株特异的,由遗传因素决定。
令人好奇的是,顺时针或逆时针的生长方向似乎是一种遗传特征:即使在相同的物种中,不同的菌株也是在不同的方向上生长的。这是细菌遵循个体 DNA 指令的另一个例子,它可以证实解决问题的行为在生物膜的集体层面上是非常复杂的,并且具有适应性。
生物膜在培养基中产生的这些几何形状及其可能的功能模式是非常迷人的。然而,奇米列斯基指出,将实验室中的行为适用到自然微生物群落上还有许多工作要做。
奇米列斯基指出,“大多数天然生物膜是多物种的生态系统,而天然生物膜内部的细胞通常生长得更慢。”他继续说道,“我喜欢思考我们在培养皿中培养细菌的方式:一个单一物种独自存在,处于生长的最佳温度下,并拥有生长所需的一切条件,就好像直接把物种的存活能力调高了。在实验室条件下,研究人员可以研究哪些基因参与复杂的多细胞行为,他们可以测量该菌种的适应性。但在自然环境中,由于营养物质有限或与其他物种竞争,生物膜通常不会按照完全与实验室相同的模式形成。他说:“因此,同样的生物学规律可能会出现在你的后院的土壤颗粒中,在更小的尺度上,而且在更长的时间周期内,”当然,这肯定没那么容易被拍摄下来。
隔绝与操控
生物膜的行为证明了细菌的能力和开放性,但这种开放性是有限度的,正如这种环境中有几个共存的生物膜一样。在这里,由相同的细菌或高亲缘性的菌株组成的相邻生物膜自由地融合在一起。但是由不同的细菌组成的相邻生物膜保持了自己的独特性,甚至可能试图消灭或控制彼此。
在这个培养皿中,几种不同的枯草芽孢杆菌菌株并列生长。生物膜可以区分不同的细菌菌株,它们可以与近亲相融合,但与其他菌株形成边界。
生物膜对其他种类的菌株非常不宽容,它们投入了大量“资源”生产表面活性物质,细胞外基质和其他分子——细菌学家将这些归类为生物膜的公共财产,因为负责生产的细菌是为其群落中的其他成员分泌的。这些细菌小心翼翼地保护着这些公共财产,防止膜外的游离细胞首先利用它们、获得大量的好处。
生物膜以不同的方式阻挡这样的游离细胞。例如,这幅图像中的枯草芽孢杆菌落采用“亲缘识别”的策略,菌落分泌的一种抗生素对其他物种有毒,但对其本身不具有毒性。奇异变形杆菌(Proteus mirabilis)采用以“自身识别”为基础的方式捍卫自己的利益:奇异变形杆菌的生物膜检查侵入细胞,用类似矛状的结构刺入任何入侵者,并注入毒物,杀死几乎所有与之密切相关的物种。
在以下图片中,天蓝色链霉菌(Streptomyces coelicolor)生物膜中的颜色表现了细菌产生的天然色素。生物膜色素的价值并不十分清楚,但可能与其颜色无关。确切地说,这些色素分子通常在不同方面具有生物活性。奇米列斯基说:“这段视频中所看到的蓝色颜料是放线菌紫红素 (actinorhodin),这是一种抗生素,”但他补充说,在这个时候这个术语是个误导。“相对于自然界的情况而言,杀死或生长抑制通常只发生在浓度非常高的放线菌紫红素的环境中。”因此,他说,“有一种新兴的观点认为大多数抗生素的生态功能可能不是杀死细胞。相反,这些生物活性分子可能是对其他细胞的信号或发育线索。
生物膜可以使用生物活性色素作为操纵其共享环境中其他微生物行为的信号。
考尔特实验室的另一位研究人员格莱布·皮什坎尼(Gleb Pishchany)在一份研究报告中回应了这种观点,他研究了不同类型的细菌如何共存。他写道:“一个有趣的可能是,在自然生态系统中,链霉菌使用较低浓度的色素和其他生物活性分子,作为在多物种微生物群落之间交换的信号。色素可能有助于同居的不同种类的细菌抑制彼此的排外本能,从而维持一种更加具有合作精神、富有成效的集体生活。
单反相机捕捉了这些令人震惊的微生物群落照片。奇米列斯基在工作台上工作时,用微镜头拍摄了它的静态图像,而视频则是在一个专门用于延时摄影的显微镜培养器中制作的。他设置相机每隔 10 分钟拍摄一张照片,每隔一两分钟便增加拍摄的频率,以便捕捉更快地动作,比如黏菌的运动。最后,这些视频中的微生物的运动速度通常是它们实际速度的 5 千到 5 万倍。奇米列斯基不使用后期染色来美化图像:除了对某些环境中的细胞外基质使用染料,他的大多数作品都展示了微生物的天然色彩。
奇米列斯基通常在 30°C 下培育细菌菌落,在这个温度下,他可以用几周时间来收集生长缓慢的物种的图像。少数照像机会出现机械故障:因为记录微生物行为所需的拍摄数量非常之大,以至于快门最终在数十万次点击之后坏掉了。
原文链接:
https://www.quantamagazine.org/the-beautiful-intelligence-of-bacteria-and-other-microbes-20171113/
阅读更多
▽ 故事
· 结果无法重复!诺奖得主撤稿《自然•化学》论文,表示“这真的很丢脸”
· 在美国做博后收入差距有多大?13000名博后的工资调查结果或许超出你的想象
▽ 论文推荐
· 研究发现抵制语法变化大约是白费力气 | Nature 论文推荐
· 地球自转谜之变慢:专家预测2018年地震频率将会上升 | Geophys. Res. Lett. 论文推荐
· 人类已至巅峰,并将由此走向下坡 | Frontiers in Physiology 论文推荐
▽ 论文导读
内容合作请联系
keyanquan@huanqiukexue.com